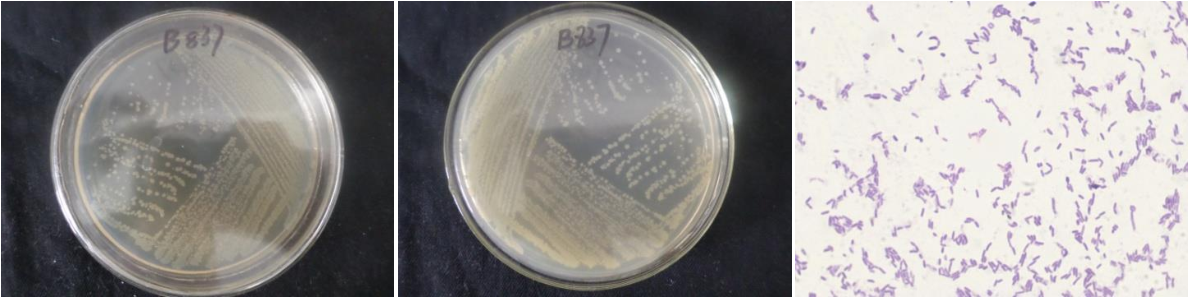

Loading...
| StrainNO | B837 |
| Classification | Bacillus |
| 16s rDNA sequence | ATGCAAGTCGAGCGAATCTTTAGGAGCTTGCTCCTGAAGGTTAGCGGCGGACGGGTGAGTAACACGTGGGCAACCTGCCTGTAA GACTGGGATAACTTCGGGAAACCGGAGCTAATACCGGATAATCCTTTCCCTCTCATGAGGGAAAGCTGAAAGTCGGTTTCGGCT GACACTTACAGATGGGCCCGCGGCGCATTAGCTAGTTGGTGAGGTAACGGCTCACCAAGGCGACGATGCGTAGCCGACCTGAGA GGGTGATCGGCCACACTGGGACTGAGACACGGCCCAGACTCCTACGGGAGGCAGCAGTAGGGAATCTTCCGCAATGGACGAAAG TCTGACGGAGCAACGCCGCGTGAGCGATGAAGGCCTTCGGGTCGTAAAGCTCTGTTGTTAGGGAAGAACAAGTATCGGAGTAAC TGCCGGTACCTTGACGGTACCTAACCAGAAAGCCACGGCTAACTACGTGCCAGCAGCCGCGGTAATACGTAGGTGGCAAGCGTT GTCCGGAATTATTGGGCGTAAAGCGCGCGCAGGCGGTCCTTTAAGTCTGATGTGAAAGCCCACGGCTCAACCGTGGAGGGTCAT TGGAAACTGGGGGACTTGAGTGCAGAAGAGGAAAGCGGAATTCCACGTGTAGCGGTGAAATGCGTAGAGATGTGGAGGAACACC AGTGGCGAAGGCGGCTTTCTGGTCTGTAACTGACGCTGAGGCGCGAAAGCGTGGGGAGCAAACAGGATTAGATACCCTGGTAGT CCACGCCGTAAACGATGAGTGCTAAGTGTTAGAGGGTTTCCGCCCTTTAGTGCTGCAGCTAACGCATTAAGCACTCCGCCTGGG GAGTACGGCCGCAAGGCTGAAACTCAAAGGAATTGACGGGGGCCCGCACAAGCGGTGGAGCATGTGGTTTAATTCGAAGCAACG CGAAGAACCTTACCAGGTCTTGACATCCTCTGACACTCCTAGAGATAGGACGTTCCCCTTCGGGGGACAGAGTGACAGGTGGTG CATGGTTGTCGTCAGCTCGTGTCGTGAGATGTTGGGTTAAGTCCCGCAACGAGCGCAACCCTTGTTCTTAGTTGCCAGCATTCA GTTGGGCACTCTAAGGAGACTGCCGGTGACAAACCGGAGGAAGGTGGGGATGACGTCAAATCATCATGCCCCTTATGACCTGGG CTACACACGTGCTACAATGGATGGTACAAAGGGCTGCAAAACCGCGAGGTTAAGCCAATCCCATAAAACCATTCTCAGTTCGGA TTGTAGGCTGCAACTCGCCTACATGAAGCCGGAATCGCTAGTAATCGCGGATCAGCATGCCGCGGTGAATACGTTCCCGGGCCT TGTACACACCGCCCGTCACACCACGAGAGTTTGTAACACCCGAAGTCGGTGGGGTAAC |
| Strain Morphology Photos | |
| Morphological Description | Colony round;clam white;edge neatly;steamed bun shaped;bright;sticky;strain:Rod;having spore;Spores are intermediate |